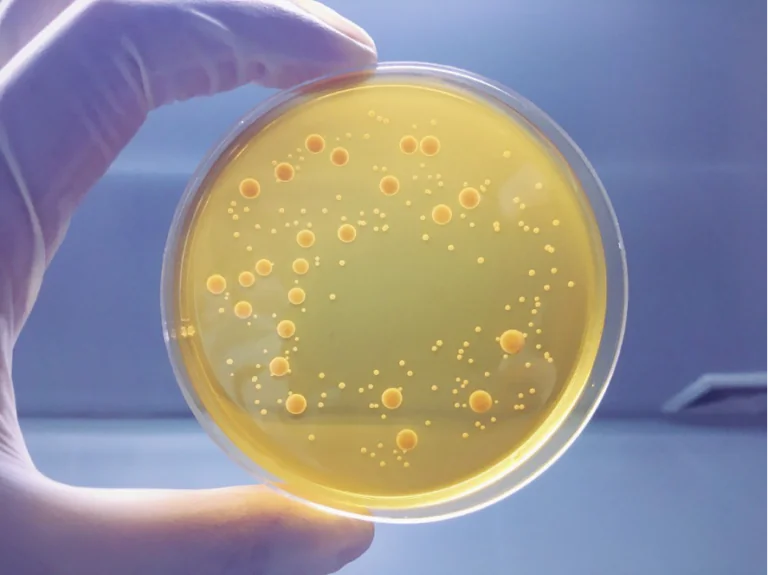

| Tipos de pago | Contado, 6 Meses, 3 Meses, 2 Meses |
|---|
Sin categorizar
Curso de Orinas e Interpretación de Sedimento Urinario + Curso gratuito de Urocultivo
El precio original era: $80.000,00.$50.000,00El precio actual es: $50.000,00.
Con Mercado Pago llévalo ahora y paga mes a mes.
Saber más

Valoraciones
No hay valoraciones aún.